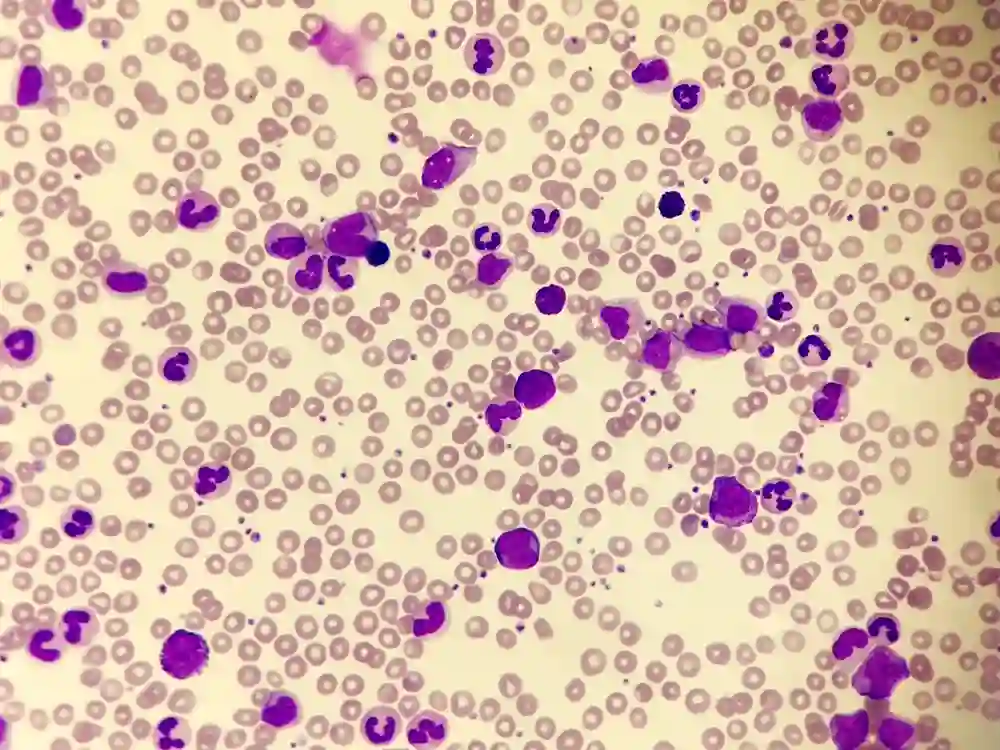

Chronic myeloid leukemia (CML)
It is also known as chronic myelogenous leukemia, and it is a slow-progressing disease affecting the bone marrow. Chronic myeloid leukemia features an abnormal chromosome called the Philadelphia chromosome, which is important to make the diagnosis.
Similar to other types of leukemia, this type spreads to other organs, and the aberrant cells infiltrate almost every organ of the body.
Treatment options for chronic myeloid leukemia typically include immunotherapy, radiation therapy, or chemotherapy. However, some patients may require a stem cell transplant to cure the disease, depending on their age and health parameters.
There’s more information about chronic myeloid leukemia in a particular article we have written for that purpose.